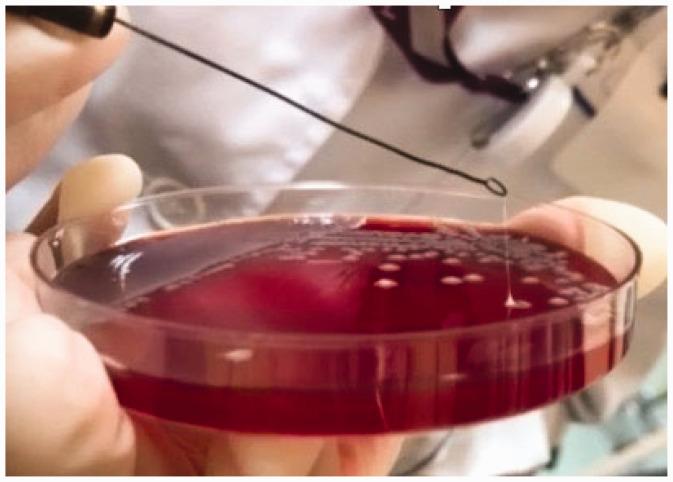
https://cdn.ncbi.nlm.nih.gov/pmc/blobs/2f9c/8969510/6748e6f66306/10.1177_03000605221084881-fig6.jpg

侵袭性综合征:肝脓肿合并肺脓肿、眼内炎和脑脓肿一例。
invasion syndrome: a case of liver abscess combined with lung abscess, endophthalmitis, and brain abscess.
机构信息
Beijing Tsinghua Changgung Hospital, School of Clinical Medicine, Tsinghua University, Beijing 102218, China.
出版信息
J Int Med Res. 2022 Mar;50(3):3000605221084881. doi: 10.1177/03000605221084881.
invasion syndrome (KPIS) is a critical multi-site infection that is usually caused by highly virulent . It is relatively common in Asian patients with diabetes and leads to sepsis, which has a high mortality rate. We report the case of a man in his early 40s who presented to the hospital with blurred vision in his left eye of 7 days' duration and fever of 1 day's duration. After a complete examination, he was diagnosed with KPIS on the basis of his liver abscessation, lung abscessation, endophthalmitis of the left eye and brain abscessation. After needle puncture and drainage of the left eye and liver abscess and anti-bacterial treatment with meropenem, the patient recovered well. When KPIS is suspected, attention should be paid to the sites of infection and the selection of the most appropriate antibiotics, but the most important aim should be to drain the lesions in a timely manner to improve the patient's prognosis.
眼内炎、肝脓肿、肺脓肿及脑脓肿,诊断为侵袭性综合征(KPIS)。给予左眼眼内脓肿穿刺引流、肝脓肿穿刺引流,以及美罗培南抗感染治疗后,患者病情好转。当怀疑 KPIS 时,应注意感染部位和选择最合适的抗生素,但最重要的是及时引流病变,以改善患者预后。